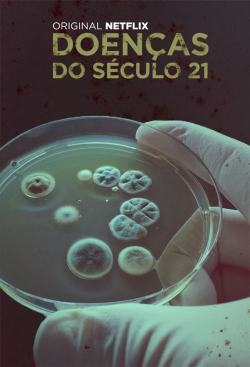

Movies of tags Ted
Filter
Film Type
Sort by
Genre
Country
Release